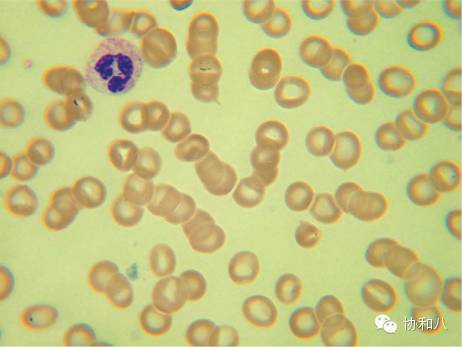
是COOMBS，不是Combs|一页手册·协和八

小编按:说到各种神秘高冷的试验,不得不提的便是历史长达 50 年的 Coombs 试验,今天就让南通大学附属医院干细胞实验室的 alandream 给大家揭开 Coombs 冷美人的神秘面纱!
1
前世今生:互相对视却不能拥抱彼此
Coombs 试验是由剑桥免疫学家 Robin Coombs 与两位医师 Arthur Mourant 及 Rob Race 在 1946 年一起建立的实验方法,用于检测表面结合有抗体和或补体的红细胞(致敏红细胞),判断溶血性贫血是否与免疫介导有关。
人体内红细胞之间保持着一定的距离,其主要机制是红细胞膜外的电荷相互排斥:红细胞膜表面本身带负电(zeta 电势),悬浮于电解质溶液(如生理盐水)时会在红细胞膜周围形成带正电荷的电子云,同性相斥,从而使两个相邻的红细胞保持一定距离(图 1,一般情况下是 25nm,最短不会低于 18nm)而不凝集。

图 1 红细胞膜外电荷互斥机制
来源:Henry’sClinical Diagnosis and Management by Laboratory Methods, 21th edition
2
是谁让我们苦苦相望
一旦干扰离子云形成,比如血浆内出现异常的单克隆免疫球蛋白(M 蛋白),影响了膜表面的静电荷,或使用右旋糖酐、羟乙基淀粉以及静脉用X线造影剂,不断做布朗运动中的圆盘状的红细胞可以因为面积较大的圆盘面之间的相互作用而一层层的叠起来,形成所谓的缗钱样结构(图 2、图 4),不过需要注意的是缗钱样形成不是凝集,而是单向的叠起,用生理盐水洗涤去除异常物质后该现象即消失;其他机制可能还涉及细胞膜表面的亲水基团和水分子相互作用形成表面张力,保持红细胞有一定距离而不凝集。
图 2 红细胞緡钱样结构

图 3 红细胞冷凝集
图 2、图 3 来源:Goldman's cecil medicine 24th edition

图 4 缗钱样结构的形成
来源:阿月浑子绘制
3
我们在一起的代价,是凝集
早在 1903 年,研究者就用显微镜发现红细胞的凝集现象(图 3),凝集不是凝固,正常情况下不会发生。因为红细胞凝*会集**导致血流滞缓甚至诱发血栓形成。早年间人们观察到的凝集现象实际是 IgM 介导的冷凝集素性溶血性贫血,由于 IgM 分子五聚体大,作用距离长,可以使红细胞发生凝集,故又称为完全抗体,同时,IgM 能结合补体从而形成补体致敏的红细胞。IgG 却鞭长莫及,称为不完全抗体。
1946 年,虽然人们已经在临床发现溶血性贫血这一现象, 在当时无法进一步区分(如新生儿溶血性贫血原因多种多样),来自剑桥的免疫学家 Robin Coombs 用兔抗人免疫球蛋白血清把免疫相关的新生儿溶血性贫血和先天性红细胞异常导致的溶血性贫血区分开来,从而建立了 Coombs 试验。
所谓的 Coombs 试剂,就是用人正常纯化的免疫球蛋白免疫家兔后获得的含多抗的血清,其中分别含有抗免疫球蛋白和抗补体的抗体。可使致敏的红细胞发生凝集,机理如下(图 5):直接 Coombs 试验是用于检测已粘附在红细胞表面的不完全抗体;间接 Coombs 试验用于检测游离在血清中的不完全抗体。

图 5 直接及间接 Coombs 试验
来源:The role of the Coombs test in evaluating hemolysis in adults. CMAJ. 2006, 174(3): 305-7.
4
Coombs 试验知多少?
现在,由于实验的发展,原来的多抗细分为多种单抗,实验操作也有三种不同的方法,从纯手工的普通试管法到半手工的微柱凝胶卡到全自动的固相法各个实验的灵敏度和特异性还不相同,各个方法得出的结论并不一致,加上有些医院检验科做对照但有的医院觉得繁琐而不做对照,所以在解读 Coombs 试验结果前,除了有病史背景外,需要问清楚实验室的实验试剂和实验方法。

图 6:3 种直接 Coombs 试验的检测方法
来源:The direct antiglobulin test: a critical step in the evaluation of hemolysis Am J Hematol. 2012, 87(7): 707-9.
Coombs 试验分直接(Direct antiglobulin test,DAT)和间接(indirect antiglobulin test, IAT),DAT 检测的是吸附有 IgG 或者/和补体的红细胞(致敏红细胞),IAT 检测的是游离在血浆中能和红细胞结合的 IgG(一般是输血科用于检测不规则抗体或者用于配血),一般来说临床医生需要知道的是 DAT,其作用主要是判断溶血性贫血的原因是否与免疫有关。
5
Coombs 试验:如何读懂你
红细胞胞膜表面吸附有抗体和/或补体可见于几种情况:
❖自身免疫性溶血性贫血(AIHA),在大多数情况下,如产生针对红细胞自身抗原的抗体是免疫障碍的唯一证据,该综合征被称为「特发性」AIHA。然而 AIHA 可以发生于以免疫系统异常为特征的一系列疾病状态下,如先天性免疫系统异常、系统性红斑狼疮等自身免疫性疾病、恶性肿瘤尤其是淋巴增殖系统肿瘤,以及某些感染(最常为病毒感染)后。根据抗体的类型和特性,可进一步分出温抗体性、冷抗体性、混合型及阵发性寒冷性血红蛋白尿四种情况;
❖同种异体免疫性溶血:见于输血,包括急性、迟发性溶血性输血反应、供者输入过路抗体,免疫介导的新生儿溶血病,血型不合的造血干细胞移植受者的红系重建,次要 ABO 血型不合引起的过路淋巴细胞综合症(Passenger Lymphocyte Syndrome,PLS),器官移植中供者残留的淋巴细胞产生的抗体包被受者红细胞而致敏),使用药物如 IVIG 或者 RhD 免疫球蛋白(国外用于 ITP 治疗,国内暂无)后;
❖药物诱导的溶贫,机制有:药物吸附/半抗原机制(青霉素)、免疫复合物型机制(奎尼丁)、药物导致红细胞膜的抗原改变直接诱导自身抗体产生(甲基多巴、氟达拉滨)、药物诱导的非特异性免疫吸附(头孢噻吩);
❖正常人,有研究发现住院患者的血样中可有约 8% 的阳性率,即使是献血员的正常人,会有 0.1% 的阳性;
❖假阳性,患者红细胞自发性凝集,手工操作时比如过度离心或者洗涤不充分或者标本已经凝固;高丙种球蛋白血症;药物如头孢菌素可致血浆蛋白非特异性吸附于红细胞表面;静脉血混有低离子强度溶液等。
注:DAT 阴性而 IAT 阳性,可能系同种免疫抗体所致,与输血或妊娠有关,而不是自身免疫所致。

图 7 直接 Coombs 试验阳性的进一步处理